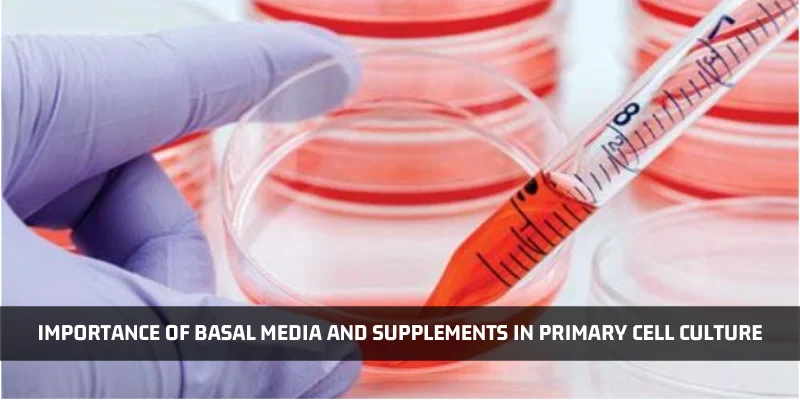
You are currently viewing Importance Of Basal Media And Supplements In Primary Cell Culture

The task of choosing cell culture media for use with your primary cells is surely daunting. Therefore, if you are thinking of replicating a formulation of media from any previously published report or if you are optimizing your nutrient or classical media, it is important to understand the consequences of this media choice for your primary cell culture maintenance and research.
Many biological researchers who work with cell lines, commonly use nutrient and classical media as they deem sufficient for cell line growth and maintenance. But Primary Cell culture requires additional nutrients for enhanced culture practice. Cell lines are more proliferative in nature with a better adaptation to 2D culture and they tend to be more resilient to cultural conditions. In the case of primary cells, they are isolated from their 3D host tissue and then transferred to a 2D environment of dish or flask.
These cells are less proliferative than cell lines and have more complex requirements for nutrition. Primary cells also have a limited lifespan and reach towards senescence faster in culture conditions. Due to these special features, special media is a better choice for primary cell cultures and this calls for optimized basal media with supplementation. Specialty media are designed to be used with little or no serum component and supplemented with growth factors, lipids, and hormones. These components allow the proper optimization for growing the specific cell type.
Researchers have done some studies to choose the correct form of basal media and supplementation in form of culturing primary cells with company-composed specialty media and DMEM/F12, as this is a good supportive basal medium, for comparing the growth and maintenance of primary cells. Moreover, some studies also compared this medium with higher serum levels (10%) versus lower serum levels (5%) in combination with endothelial cell growth supplements, hormones, and growth factors for the optimized growth of endothelial cells. Studies showed that primary cells grew more quickly with the formulation having 5% serum as compared to 10%, thus suggesting that a lower serum formulation, in combination with growth factors and hormones, is better for primary endothelial cell proliferation.
But better than DMEM/F12 and other supportive basal media, the basal media closest to the extracellular matrix (ECM) environment showed enhanced growth and better compact morphology. Thus, the correct composition of specialized basal medium with growth factors and supplements, when it mimics the ECM of specific primary cells, is important to understand for having the optimum proliferation and viability of primary cells in culture. Always remember, the healthier your primary cells stay, the more relevant your results are!
At Kosheeka, we consider the complex nutrition needs of the primary cells and help you choose the best media and supplements for your cell culture. With our cell culture expertise, information, and resources, procuring primary cells, customized to your research needs, is quite an easy and affordable feat, and for any inquiries related to primary cell culture and Stem Cell Culture, contact us at info@kosheeka.com